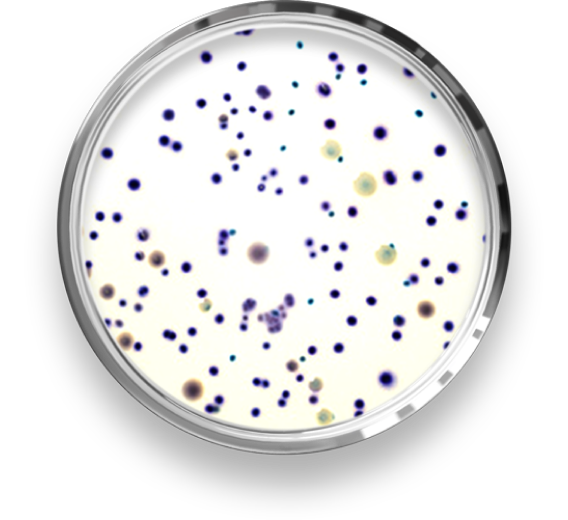

Aproveite as condições promocionais!

A revolução em testes microbiológicos para a indústria de alimentos!
Você precisa de resultados rápidos, precisos e validados internacionalmente? Conheça o RAPID’E.coli 2 da Bio-Rad!

Transforme a produtividade da sua rotina de análises com confiança!
Resultados completos em 18-24h! Incubação rápida, sem necessidade de enriquecimento e confirmação.
Enumere E.coli e coliformes com uma única placa.
Recuperação eficaz de cepas de E.coli, mesmo sob estresse de cloro e seletividade incomparável contra flora hídrica interferente
AOAC, Health Canada, NordVal para alimentos.
NF Validation para alimentos e água.
Coloração contrastante para leitura e interpretação dos resultados facilmente! Seja você um especialista ou um iniciante.
A flexibilidade do RAPID’E.coli 2 se adapta às suas necessidades, otimizando seus processos e resultados.

O RAPID’E.coli 2 é aprovado pela EPA dos EUA, garantindo que você tenha uma solução confiável para análises de água, enquanto também oferece desempenho excepcional em análises de alimentos. Saiba mais sobre esta aprovação!

Conheça nossas ofertas especiais e condições exclusivas para a linha RAPID’. Aproveite essa oportunidade única para elevar sua análise de segurança de alimentos a um novo patamar.
Porque sabemos muito bem do que estamos falando! Confira você mesmo:

CARTILHA
Baixe grátis nossa cartilha
e desvende o RAPID’E.coli 2.

CARTILHA
Baixe grátis nossa cartilha
e desvende o RAPID’Salmonella.

WEBINAR
Você está pronto(a) para elevar suas análises microbiológicas a um novo patamar de eficiência? Desbloqueie gratuitamente seu acesso ao Webinar “Otimização do Workflow de Análises Microbiológicas a partir da Cultura Tradicional”, com o expert Marcelo Silva, e eleve o padrão das suas análises microbiológicas de alimentos!

CURSO
Inscreva-se no curso da Universidade Bio-Rad e garanta seu certificado gratuitamente. São dois módulos repletos de conhecimentos técnicos e científicos em conceitos atuais da Segurança dos Alimentos, principalmente no nicho de análises microbiológicas, com aulas dinâmicas preparadas por experts da Bio-Rad, mestres e doutores em diferentes áreas da Ciência.


Entre em contato conosco hoje mesmo e descubra os benefícios do RAPID’E.coli 2 da Bio-Rad.

Bio-Rad Brasil © Todos os direitos reservados. Política de privacidade.
| Cookie | Duração | Descrição |
|---|---|---|
| cookielawinfo-checkbox-analytics | 11 months | This cookie is set by GDPR Cookie Consent plugin. The cookie is used to store the user consent for the cookies in the category "Analytics". |
| cookielawinfo-checkbox-functional | 11 months | The cookie is set by GDPR cookie consent to record the user consent for the cookies in the category "Functional". |
| cookielawinfo-checkbox-necessary | 11 months | This cookie is set by GDPR Cookie Consent plugin. The cookies is used to store the user consent for the cookies in the category "Necessary". |
| cookielawinfo-checkbox-others | 11 months | This cookie is set by GDPR Cookie Consent plugin. The cookie is used to store the user consent for the cookies in the category "Other. |
| cookielawinfo-checkbox-performance | 11 months | This cookie is set by GDPR Cookie Consent plugin. The cookie is used to store the user consent for the cookies in the category "Performance". |
| viewed_cookie_policy | 11 months | The cookie is set by the GDPR Cookie Consent plugin and is used to store whether or not user has consented to the use of cookies. It does not store any personal data. |
Preencha o formulário e receba o material!
Preencha o formulário e receba o material!
Preencha o formulário e receba o material!